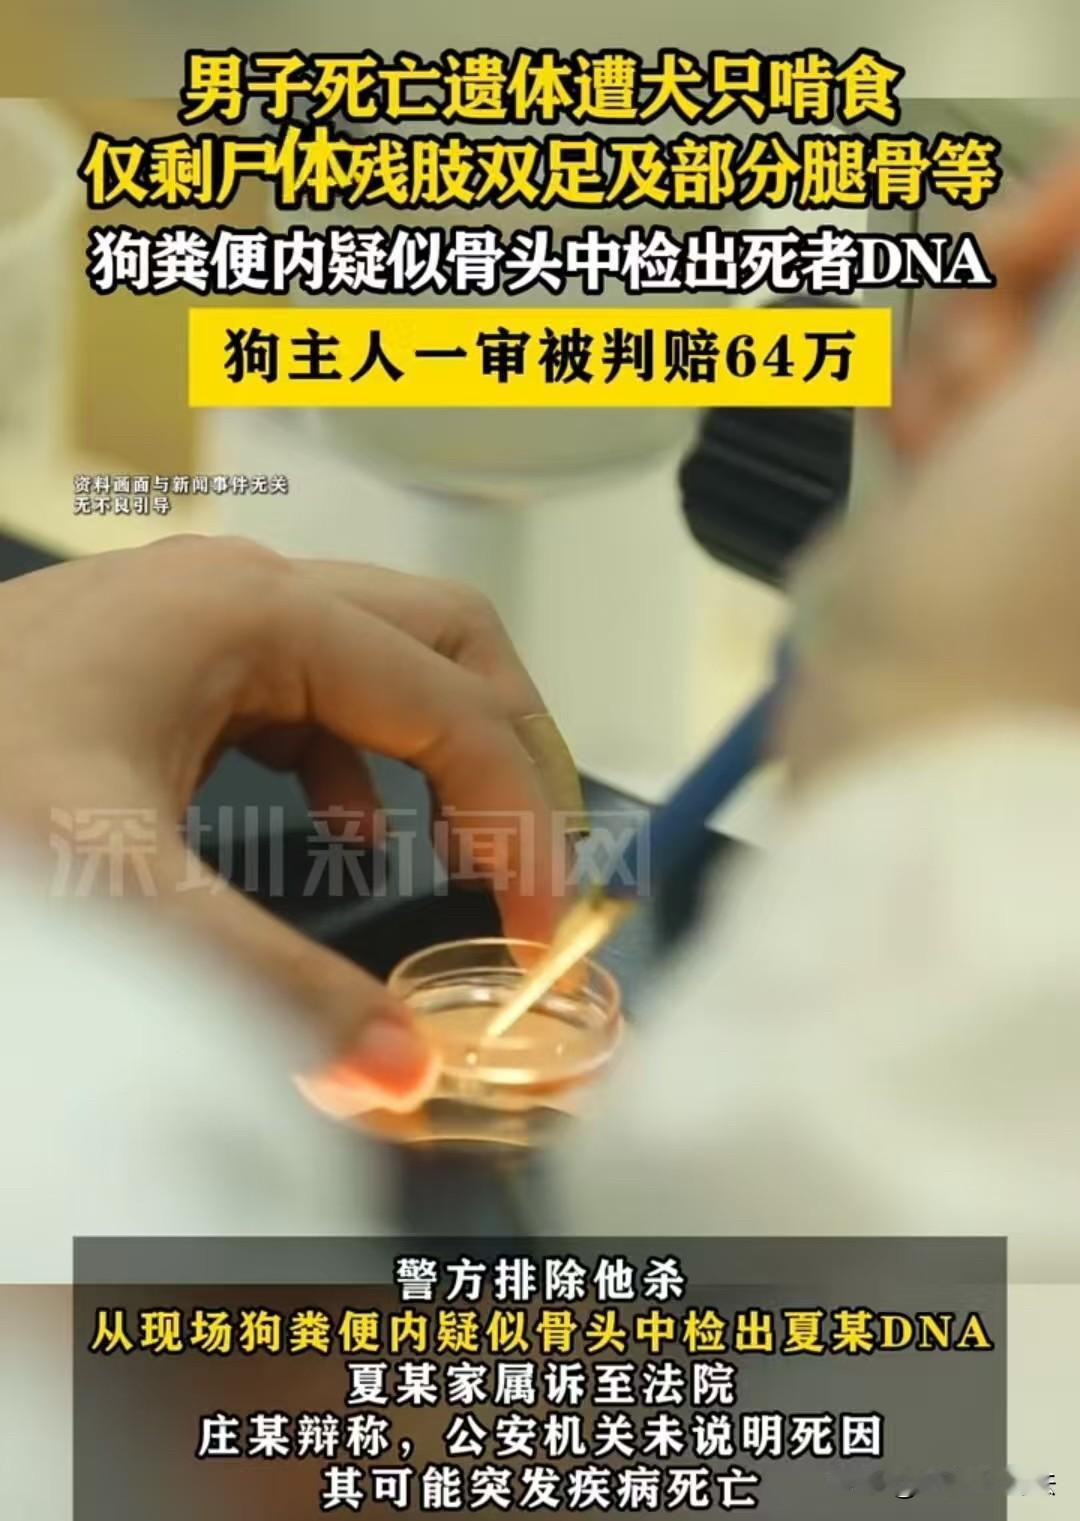

内蒙古,60岁的老人被雇主的11条散养狗啃食,警方并未明确死因。不过,家属要求雇主赔偿64万元,而雇主则表示,老人有可能是因病去世,和自己没关系。法院则认为,雇主一个月未联系老人,存在管理失责,需承担相应责任。 2024年12月的内蒙古陈巴尔虎旗,草原被皑皑白雪裹得严严实实,零下二十多度的寒风像刀子一样刮过荒芜的牧业点。 16日清晨,雇主庄某踩着厚雪来到距家14公里的牧业点,刚推开吱呀作响的铁门,一股腥气就扑面而来——六旬雇工夏某直挺挺倒在煤堆旁,没了一丝气息,而他养的11条狗正围在一旁,撕咬着地上的骨头,夏某的遗体只剩残肢双足和部分腿骨,头部、上肢早已不见踪影。 庄某瞬间腿软,连滚带爬地退到门外报警。他怎么也没想到,自己只是14天没来看过牧业点,竟会发生这样的惨剧。 夏某是庄某口头雇佣的打更工人,月工资1500元,双方既未签订书面劳动合同,也未购买任何保险。 偌大的牧业点只有夏某一人值守,庄某图省事,把11条狗留在牧业点看门,却只随手拴了2条,剩下9条全散养在院里,甚至连基本的监控和安全防护措施都没装。 警方赶到时,现场的惨状让见惯了大案的民警都皱紧了眉。 法医对现场残留的骨头碎片进行检测,又在狗的粪便里发现了疑似人体组织,DNA比对结果出来后,所有人的心都沉了下去:这些碎片正是夏某的。 尽管最终排除了他杀,警方未明确夏某具体死因,庄某则辩称其可能突发疾病死亡,但遗体遭群犬啃食的事实,还是让远在老家的家属崩溃大哭。 家属很快将庄某告上法庭,要求他为这份失职付出代价。 可庭审时,庄某却满脸不服,拍着桌子辩称:“他是自己病死的,跟我有啥关系?警察都没说死因,凭什么让我赔钱?”他甚至觉得,自己雇佣夏某给其报酬,已经是仁至义尽。 但法院的判决,狠狠击碎了他的侥幸。 法官当庭指出,庄某作为雇主,既未保障雇员的工作安全,又对散养的狗群疏于管理,更在长达14天的时间里对独自值守的夏某不闻不问,这种种失职,正是悲剧发生的关键。 即便夏某的直接死因是疾病,庄某也必须为遗体损毁和安全保障缺失承担民事赔偿责任。 最终,法院一审判决庄某赔偿夏某家属死亡赔偿金、丧葬费等共计641237元,其中5万元专门用于弥补家属因夏某遗体损毁遭受的精神创伤。 拿到判决书的那一刻,夏某的家属红着眼眶说:“钱换不回亲人的命,只希望以后再也没人因为这种失职,落得这样的下场。” 可这起悲剧留下的教训却格外沉重。一份潦草的口头雇佣,一次漫不经心的失联,一群无人管控的狗,最终让一条鲜活的生命以如此惨烈的方式落幕,也让雇主为自己的疏忽,付出了沉重的法律代价。 一、仅口头约定雇佣、未签合同未买保险,事实劳务关系受法律保护。 《民法典》第一千一百九十二条:个人之间形成劳务关系,提供劳务一方因劳务受到损害的,根据双方各自的过错承担相应的责任。 双方存在“提供劳务+支付报酬”的事实,构成合法劳务关系,雇主需承担安全保障义务。 二、 雇主散养11条狗导致老人遗体被啃食,需承担动物饲养人责任。 《民法典》第一千二百四十五条:饲养的动物造成他人损害的,动物饲养人或者管理人应当承担侵权责任;但是,能够证明损害是因被侵权人故意或者重大过失造成的,可以不承担或者减轻责任。 雇主未对狗群采取有效安全措施,且无证据证明老人存在故意过错,需担责。 三、民警未明确老人具体死因,雇主仍需承担赔偿责任。 《民法典》第一千一百九十八条:宾馆、商场、银行、车站、机场、体育场馆、娱乐场所等经营场所、公共场所的经营者、管理者或者群众性活动的组织者,未尽到安全保障义务,造成他人损害的,应当承担侵权责任。 雇主未尽到安全保障与巡查义务,其过错与遗体损毁后果相关,需赔偿。 四、雇主“民警没定死因,凭啥我赔”的辩解无法律依据。 《民法典》第一千一百六十五条:行为人因过错侵害他人民事权益造成损害的,应当承担侵权责任。 雇主存在长期漠视雇员安全、疏于管理狗群的过错,辩解不成立,需担责。 对于此事,大家如何看?素材来源于深圳新闻网,2025年12月13日